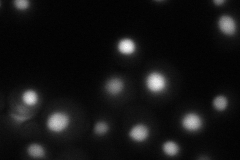
YLR107W
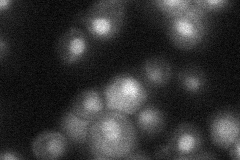
YLR107W

View description
RNA exonuclease; required for maturation of the RNA component of RNase MRP; functions redundantly with Rnh70p and Rex2p in processing of U5 snRNA and RNase P RNA; member of RNase D family of exonucleases
Localization:
Intensity:
Fold change:
Significance:
-
C’ GFP library in SD

nucleus20.5 -
N' NOP1pr-GFP in SD

nucleus51.4139 -
N' TEF2pr-mCherry in SD
nucleus45.0534 -
N' NATIVEpr-GFP in SD
nucleus25.0542 -
N' TEF2pr-VC and Cyto-VN in SD

#N/A0 -
C’ GFP library in SD+DTT

nucleus24.971.21No -
C’ GFP library in SD+H2O2

nucleus21.341.04No -
C’ GFP library in Starvation Media

nucleus16.510.8No -
C’ GFP library on the background of Pup2-DaMP

nucleus -
C’ GFP library on the background of CCT mutant

nucleus20.50621No
